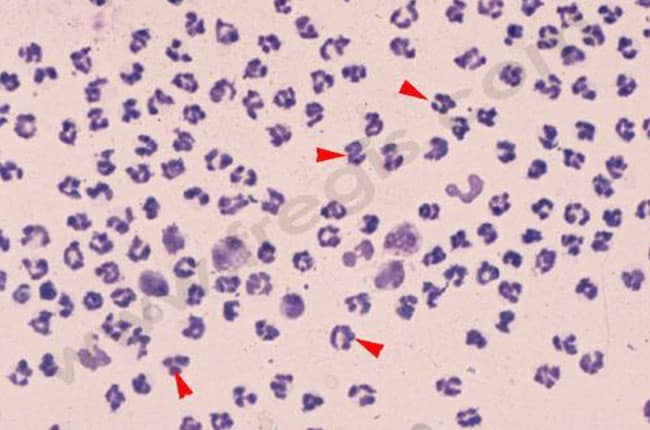

24h/24 - 7j/7
24h/24 - 7j/7

La polyarthrite chez le chien est une maladie qui touche plusieurs articulations qui deviennent alors douloureuses. Le plus souvent la polyarthrite est due à un dysfonctionnement du système immunitaire (on parle alors de polyarthrite dysimmunitaire ou de polyarthrite idiopathique). C’est la forme la plus courante d’arthropathie (maladie articulaire) chez le chien. La polyarthrite est associée dans 25 % des cas à des infections chroniques éloignées de l’articulation, dans 15 % à des maladies gastro-intestinales et dans d’autres cas à des affections cancéreuses éloignées de l’articulation. Parfois, une méningite peut y être associée. Pour environ 50 % des cas, aucune affection ou cause sous-jacente n’est identifiée.
Parmi les races considérées comme prédisposées, on trouve : le Berger allemand, le labrador retriever